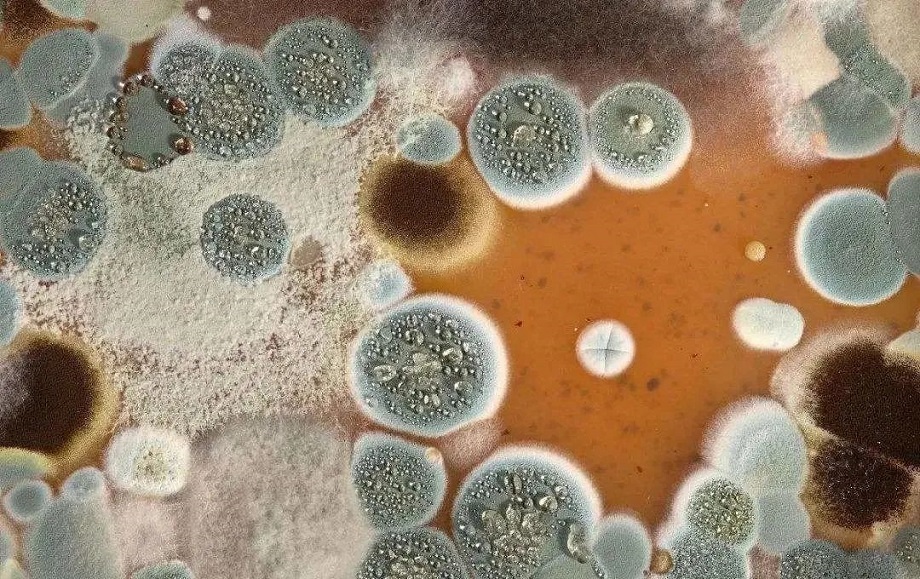
霉菌 霉菌

霉菌對塑料制品的危害有多大?這也是抗菌塑料存在的價值
霉菌是一種多細胞微生物,是形成分枝菌絲的真菌的統稱,菌絲呈長管狀,寬度約2~10微米,霉菌在自然界中種類繁多,約有10萬種,分布極其廣泛,在土壤、江河、湖泊以及自然物體上都有存在。在潮濕溫暖的環境下,霉菌極易生長,能在培養基上快速繁衍成絨毛狀或棉絮狀絲狀體,并依靠形形色色無性或有性孢子進行繁殖。
塑料發霉的原因
塑料中的主要成分樹脂具有大分子碳氫長鏈結構,不易滋生和繁衍霉菌。
但在生產中加入了各種小分子的添加劑,比如脂肪酸增塑劑、軟磷脂分散劑、潤滑脂、抗氧劑等。這類物質為微生物生長提供了營養物質,使得霉菌寄生和繁殖。
塑料霉變帶來的影響
塑料制品的霉變會使其性能受損,導致使用壽命縮短,并嚴重影響到塑料制品或含有塑料部件的產品的可靠性。

受損包括直接和間接兩類現象。直接受損是造成材料本身的腐爛和老化。
間接受損是霉菌的生長給其他零部件或功能造成的破壞,主要有以下幾種:
一是損壞底材,在運輸和使用中沾在制品表面的油脂、汗跡滋生的霉菌,能損壞底材,進而通過底材侵蝕其他內部材料。
二是對電路造成破壞,由于霉菌是導電體,生長在絕緣材料上會構成電氣回路,改變材料的絕緣電阻性能,正常使用時就容易出現短路,影響電器性能。
三是降低光學儀器的精密度,在儀器內部生長的菌會減弱光線的透過率,而且霉菌就像一個充滿水的海綿,會使裝置內部保持較高的濕度,零部件受潮,性能下降,進而致使整個系統的精密度和靈敏度降低。
如何避免?
為盡量降低或避免霉菌帶來的危害,我們可以從塑料的抗菌出發。其中最有效的方法就是使用具有抗菌功能的納米銀抗菌劑,現在國內塑料抗菌是個大市場。
按照組成不同,抗菌劑可分為無機抗菌劑、有機抗菌劑、天然抗菌劑、復合抗菌劑等。
內容來源:互聯網
熱門文章
-
老生常談,POM均聚甲醛和共聚甲醛的區別
POM是常見的工程塑料之一,而均聚甲醛和共聚甲醛是最常見的POM材料,二者結構相似,有很多共同點,那么二者之間有什么有什么區別?今天就跟小編一起來了解一下。一、背景1960年 美國杜邦(DuPont)公司首次將均聚物型樹脂(DELRIN)商品化。1961年 美國Celanese公司(現在的Ti
瀏覽量:10799 -
你可知道PS塑料和ABS塑料哪個好?
問:ABS塑料與PS塑料哪個好? 答:一般來說,ABS塑料性能是優于PS塑料的,你用PS塑料可以做的產品,ABS塑料一般都可以打出來,而用ABS原料可以做的產品,PS原料不一定能做出來。 如果
瀏覽量:9501 -
ETPU是什么材料?這個就是我們要了解的
ETPU是一種質地柔軟、彈性極佳,耐磨、耐撕裂、止滑性能優異的熱塑彈性體材料,廣泛應用于鞋材領域,不但適合制作運動鞋中底和內底,還適合用于抗反復沖擊、運動防護、阻尼、家
瀏覽量:8800 -
速看!耐高溫塑料匯總:8大類高耐熱工程塑料···
塑料按長期使用溫度分類,可分為通用塑料、工程塑料和高溫工程塑料,其中高溫塑料又被稱為耐熱塑料、高性能塑料、特種工程塑料等。工程塑料的長期使用溫度在100℃至150℃左右。五大工程塑料包括PA、POM、PBT、PC和PPO。通常應用于機械零件、汽車、電器電子等領域。高溫工程塑料的使用溫度在150℃以上,這類材料除了較高的耐
瀏覽量:8185 -
帶你了解POP和POE塑料的區別在哪里?
兩者沒有本質的區別,只是共聚單體含量上有所區別,絕大部分塑性體和彈性體基料都是乙烯,只有DOW的Versify、EXXON的Vistamaxx、三井的Tafmer是丙烯基,共聚單體都為辛烯(8C)、己烯(6C)或丁烯(4C),一般POE共聚單體含量高于20%,POP共聚單體小于20%,因為共聚單體含量的多少導致POE與POP的密度差異,一般POP的密度要高與POE。
瀏覽量:7614 -
聚丙烯帶你了解均聚PP和共聚PP的區別
聚丙烯,是由丙烯聚合而制得的一種熱塑性樹脂。按甲基排列位置分為等規聚丙烯(isotactic polypropylene)、無規聚丙烯(atactic polypropylene)和間規聚丙烯(syndiotactic polypropylene)三種,今
瀏覽量:6431 -
SPS是什么塑料?關于XAREC簡單介紹
間規聚苯乙烯樹脂(SPS塑料),是1985年由日本出光成功合成,并于1997年由日本出光實現工業化的純國產聚合物。(商品名《XAREC》是使用間規聚苯乙烯樹脂(SPS)的等級群的品牌。)
瀏覽量:6296 -
韓國SK材料ECOZEN與SKYGREEN的區別在哪里?
現實生活中很多透明食品容器都用不含雙酚A的透明塑膠原料,所以很多選擇韓國SK材料ECOZEN與SKYGREEN,今天小編一一帶大家分別韓國SK材料ECOZEN與SKYGREEN的區別在哪里? ECOZEN是透明耐高溫
瀏覽量:5831 -
PC抗老化一般幾年?這就是我們要了解的
PC塑料簡介(聚碳酸酯) 英文名稱:Polycarbonate 聚碳酸酯是日常常見的一種材料,PC是一種線型碳酸聚酯,分子中碳酸基團與另一些基團交替排列,這些基團可以是芳香族,可以是脂肪族,也可兩者皆有。雙酚A型PC是很重要的工業產品,PC是幾乎無色的玻璃態的無定形聚合物,有很好的光學性。現在PC的介紹已經介紹完了,那現在我們要
瀏覽量:5800 -
PC抗UV與不抗UV有何區別?
PC抗UV就是PC塑膠原料含有抗紫外線吸收劑 熱穩定劑,含有抗紫外線,耐老化,耐黃變的性能,UV是紫外線的縮寫,英文全稱為ultraviolet,紫外線波長為:10-400nm , UVA 波長在 320-390nm ,紫外線會導致設備外殼老化,暴露在戶外的設備通常需要抗uv。抗UV耐候PC原料在日常生活中,處處可見的陽光棚的板、電動車遮陽棚、瓦楞板、
瀏覽量:5773 -
POM與PA比,哪個更耐磨?
眾所周知塑料齒輪多采用POM和PA,POM因剛性和耐疲勞性高,具有更廣泛的應用,POM齒輪相對金屬齒輪有較多的優點:質量輕、工作噪音小、耐磨損、無需潤滑、可以成型較為復雜的形狀、
瀏覽量:5754 -
關于PPE/PS、你知道多少呢?
PPE/PS就是PPO,中文名稱叫聚苯醚,PPE/PS復合材料是在PPE的基礎上機上其他熱塑性材料例如PS(苯乙烯)、PA(聚酰胺,俗稱尼龍)等材料的復合材料。這樣加工成型后具有良好的幾何穩定性、化
瀏覽量:5033 -
關于PMP材料,你了解多少?
相關詞條 PMP簡介 PMP特性 PMP應用 PMP注塑 PMP簡介 PMP學名 聚4-甲基戊烯-1單體 4-甲基戊烯-1本色 聚4-甲基戊烯-1是一種高結晶透明塑料,比重為0.83,是所有塑料中最輕的。表面硬度較低,無
瀏覽量:4745 -
PC塑料耐高溫多少度?你知道嗎?
眾所周知,PC塑料具有許多獨特優勢,然而,仍有一些人對它不甚了解,那么,PC塑料到底能夠承受多高的溫度呢?根據專家的研究,PC塑料的耐高溫范圍必須控制在45度至135度之間。一旦超出這個溫度范圍,就很容易導致PC材料老化變質,并且嚴重的情況下,它的固有性質會受到影響。正因為Pc材料的特性,它包含碳酸酯基的化合物,根
瀏覽量:4623 -
聚芳砜(PASF)是什么材料?
中文名稱:聚芳砜 英文名稱:polyarylsulfone 牌號:PAS 色態:琥珀色透明顆粒 制得:由4,4`-二磺酰氯二苯醚與聯苯反應制得 應用:常用作金屬詹黏結劑。 PASF聚芳砜性能 與雙酚A型聚砜相比
瀏覽量:4503
推薦文章
-
 科思創聚氨酯彈性體助力AGV 車輪解決方案
科思創聚氨酯彈性體助力AGV 車輪解決方案
AGV(自動導引車)如今已經成為現代倉庫中的作業主力軍,這些運輸機器人精準高效拾取、移動和搬運重型貨物和材料。當汽車生產或復雜的倉庫布局依賴于全天候運行的搬運設備時,設備零件故障是不可接受的。車輪作為 AGV 易損耗的零部件之一,是 AGV 系統效率和可靠性的關鍵保障,需具備更高的性能以承受各種復雜工作環境下的日
-
 塑料顆粒的基本性能
塑料顆粒的基本性能
1.質輕、比強度高。塑料質輕,一般塑料的密度都在0.9 -2.3克/厘米3之間,只有鋼鐵的1/8 -1/4、鋁的1/2左右,而各種泡沫塑料的密度更低,約在0.01 - O.5克/厘米3之間。按單位質量計算的強度稱為比強度,有些增強塑料的比強度接近甚至超過鋼材。例如合金鋼材,其單位質量的拉伸強度為160兆帕,而用玻璃纖維增強的塑料可
-
 增韌改性尼龍塑料有哪兩個優勢呢?
增韌改性尼龍塑料有哪兩個優勢呢?
增韌改性尼龍塑料經過二十年的發展已經獲得了一大批鐵桿粉絲,尤其是在近十年來,各種尼龍專用改性助劑行業蓬勃發展,不斷有新品研發,性能上多次超越曾經認為高不可及的指標
-
 高透明PMMA原料價格為什么有高有低呢?
高透明PMMA原料價格為什么有高有低呢?
業內人士告訴我高透明PMMA原料現在的價格定位有高有低,主要的原因就是因為生產的資質不同,在進行加工生產的過程當中使用的原材料也不一樣,所以在進行銷售的過程中,價格就會
-
 耐低溫PA66塑料一般都可以耐寒多少度?
耐低溫PA66塑料一般都可以耐寒多少度?
目前耐低溫PA66塑料在我們生活當中的應用非常的廣泛,不僅擁有很好的耐熱絕緣和阻燃的效果,最關鍵的就是強度非常高而且還有很好的抗彎曲強度,在各種極限的環境下都能夠正常的
-
 共同來了解什么是紅外線穿透PMMA塑料?
共同來了解什么是紅外線穿透PMMA塑料?
生活中,大家隨處都能看到塑料制品的影子,而紅外線穿透PMMA一種有塑料材料,這種材料的透紅外性是很高的,而且具有十分突出的抗老化以及耐侵蝕的性能,與其它類型的塑料相比,
-
 無處不在的聚碳酸酯,你知道多少呢?
無處不在的聚碳酸酯,你知道多少呢?
大家對聚碳酸酯應該都不陌生的了,平時上某寶買手機殼經常會看到聚碳酸酯材質或PC材質等字眼,甚至那些手機品牌推出新手機都會說機身材質用了PC材質。 聚碳酸酯(PC)是什么?聚
-
 從汽車部件到琴弦 PA聚酰胺材料魅力四射
從汽車部件到琴弦 PA聚酰胺材料魅力四射
聚酰胺(PA),通常稱為尼龍,具有優異的機械性能,既可以制成堅硬、堅韌的材料,也可以制成柔軟、柔韌的材料。用作工程塑料時,通常加入填料和纖維,以實現特定的性能。隨著
-
 探索醫療應用TPE熱塑性彈性體
探索醫療應用TPE熱塑性彈性體
我們專門為醫療護理行業提供創新性的醫療熱塑性彈性體(TPE),其具有設計自由、符合監管要求以及系統優化的特性。我們在四個國家提供有全球的產品支持基礎設施以及專門的TPE研
-
 2019年11月25日塑膠原料實時報價
2019年11月25日塑膠原料實時報價
PE 塑膠原料 :本周市場價格小幅上漲后下滑。石化廠頻繁下調出廠價格,市場失去支撐,再加上下游需求逐漸轉弱,出貨緩慢,市場價格不斷下跌。下周油價南漳,港口庫存積壓,棚膜
















